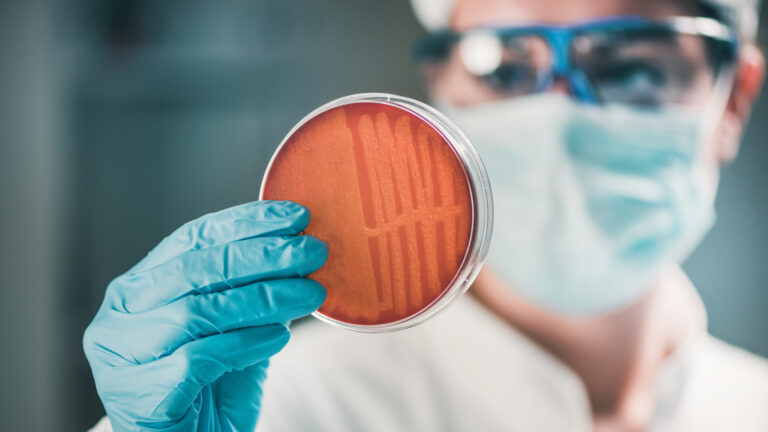

The Centers for Disease Control claims that 1 in 3 antibiotic prescriptions are unnecessary. Unnecessary antibiotics cause the body to build up a resistance to those drugs. That’s just one of the reasons why antibiotics are becoming ineffective.
And why deadly bacterial infections are getting harder to treat. So what happens when antibiotics finally fail us?
Does modern medicine die along with them? What happens to life-expectancy? Would you ever leave the house again?
Prior to the 20th century, your average life expectancy at birth would have been 47 years. But after Sir Alexander Fleming accidentally discovered penicillin, the birth of modern antibiotics increased life expectancy by at least 20 years!

The celebration was short-lived. Antibiotics have only been around for about 70 years, and already, we risk going back a century. That’s because antimicrobial resistance is on the rise.
Bacteria are evolving organisms, and like all evolving organisms, bacteria follow a process of natural selection. As bacteria mutate, they develop resistant genes, which are passed along in subsequent mutations. This “bacteria 2.0,” if you will, spreads to different hosts, passing through humans, animals, air, water, or soil.
We have an antibiotic for Bacteria 1, but it doesn’t work on 2.0. And now 2.0 is everywhere. You see the problem?
Over the past 30 years, we simply developed new antibiotics to replace the old ones. But now that antimicrobial resistance has become a lot more complex, quick cures are harder to find.

These days in the U.S. roughly 250,000 Americans die each year from bacterial infections that were once curable by antibiotics. But as more bacteria becomes resistant to antibiotics, the stats only get worse.
When antibiotics are finally rendered impotent, 1 in 9 skin infections will kill you. Be careful when you shave, and avoid paper at all costs. Even the smallest cut can get infected. Naturally, this increases the risk of any kind of surgery, and on top of that, pregnancy. If you didn’t think cancer could get any worse, think again.
Treatments like chemotherapy weaken your immune system, making you more vulnerable to infection, which is typically treated with antibiotics… But now what?
With the rise of antimicrobial resistance, we risk returning to a time when anything from a paper cut, to a handshake, to an open cough could kill you. A super-resistant form of Tuberculosis has been reported in over 100 countries and we’re running out of treatment options. We may end up reverting to the pre-antibiotics era treatment of prescribing fresh air.

So how do we prevent this antibiotic apocalypse? Fortunately, governments around the world are passing laws to prevent the misuse of antibiotics.
That means no more prescriptions for viral infections like the common cold. Farmers are also being banned from giving livestock antibiotics to boost their growth.
In the realm of science and technology, new solutions like nanochips are being developed to target bacterial cells one by one. Of course, you too can play an important role by simply maintaining basic hygiene!